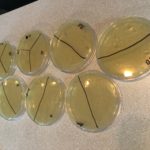

Hey Parents and Students!
We had a great Day 3! Depending on your perspective… we are halfway done, or we still have halfway to go!
Anyways, today we learned a lot about GMOs! We learned some good things and some bad things about them. We got to see how they were used in papaya and corn (bacillus to insect gene, kills insects not us…hopefully they remembered!). We watched a couple interesting videos and started our very own GMO CORN experiment. Students were asked to place the corn near their house where small animals can get to it (try to keep it dry). Our hypothesis is to test whether or not animals can tell the difference between GMO and non-GMO corn…maybe they know something we don’t!
Bring them in next week and we can record the results!
The experiment comes from this link.
We also took swab samples from around the room to grow on our nutrient agar plates (bacteria food, see picture below).
Next week we will see all the gross things that grew!
Mr. O